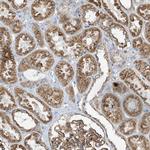
ITM2B Antibody in Immunohistochemistry (Paraffin) (IHC (P))

Search
Invitrogen
ITM2B Polyclonal Antibody
{{$productOrderCtrl.translations['antibody.pdp.commerceCard.promotion.promotions']}}
{{$productOrderCtrl.translations['antibody.pdp.commerceCard.promotion.viewpromo']}}
{{$productOrderCtrl.translations['antibody.pdp.commerceCard.promotion.promocode']}}: {{promo.promoCode}} {{promo.promoTitle}} {{promo.promoDescription}}. {{$productOrderCtrl.translations['antibody.pdp.commerceCard.promotion.learnmore']}}

Please note: We are reviewing Western blot images included in the antibody testing data in our catalog, including those provided by third parties. Unless expressly labeled or annotated as “raw-unedited”, Western blot images included in the antibody testing data in our catalog may have been edited, optimized or otherwise adjusted for presentation.
产品信息
PA5-83079
种属反应
宿主/亚型
分类
类型
抗原
偶联物
形式
浓度
规格
纯化类型
保存液
内含物
保存条件
运输条件
RRID
产品详细信息
Immunogen sequence: YFALQPDDVY YCGIKYIKDD VILNEPSADA PAALYQTIEE NIKIFEEEEV EFISVPVPEF ADSDPANIVH DFNKKLTAYL DLNLDKCYVI PLNTSIVMPP RNLLELLINI KAGTYLPQSY LIHEHMVITD RIENIDHLGF FIYRLCH
Highest antigen sequence indentity to the following orthologs: Mouse - 95%, Rat - 96%.
靶标信息
Amyloid precursor proteins are processed by beta-secretase and gamma-secretase to produce beta-amyloid peptides which form the characteristic plaques of Alzheimer disease. This gene encodes a transmembrane protein which is processed at the C-terminus by furin or furin-like proteases to produce a small secreted peptide which inhibits the deposition of beta-amyloid. Mutations which result in extension of the C-terminal end of the encoded protein, thereby increasing the size of the secreted peptide, are associated with two neurogenerative diseases, familial British dementia and familial Danish dementia.
仅用于科研。不用于诊断过程。未经明确授权不得转售。
篇参考文献 (0)
生物信息学
蛋白别名: Bri; imBRI2; Immature BRI2; Integral membrane protein 2B; OTTHUMP00000018394; Protein E25B; RP11-196P14.1; Transmembrane protein BRI
基因别名: BRI; BRI2; ITM2B
Entrez Gene ID: (Human) 9445




